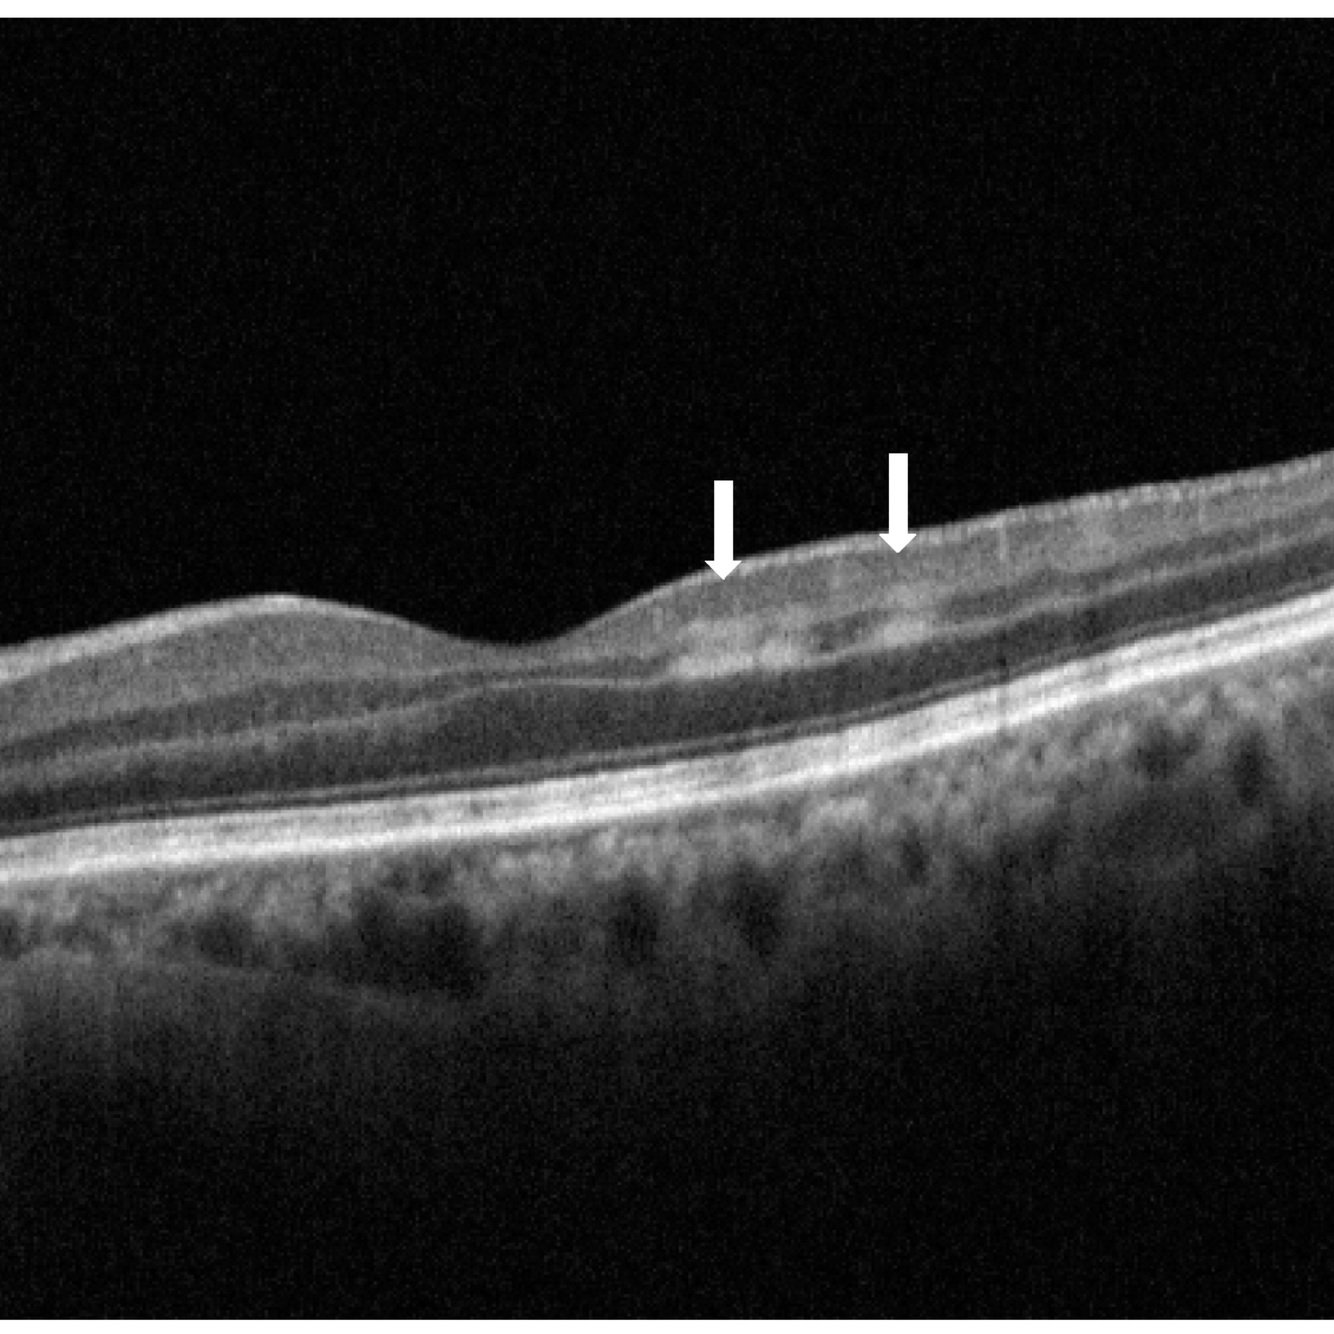
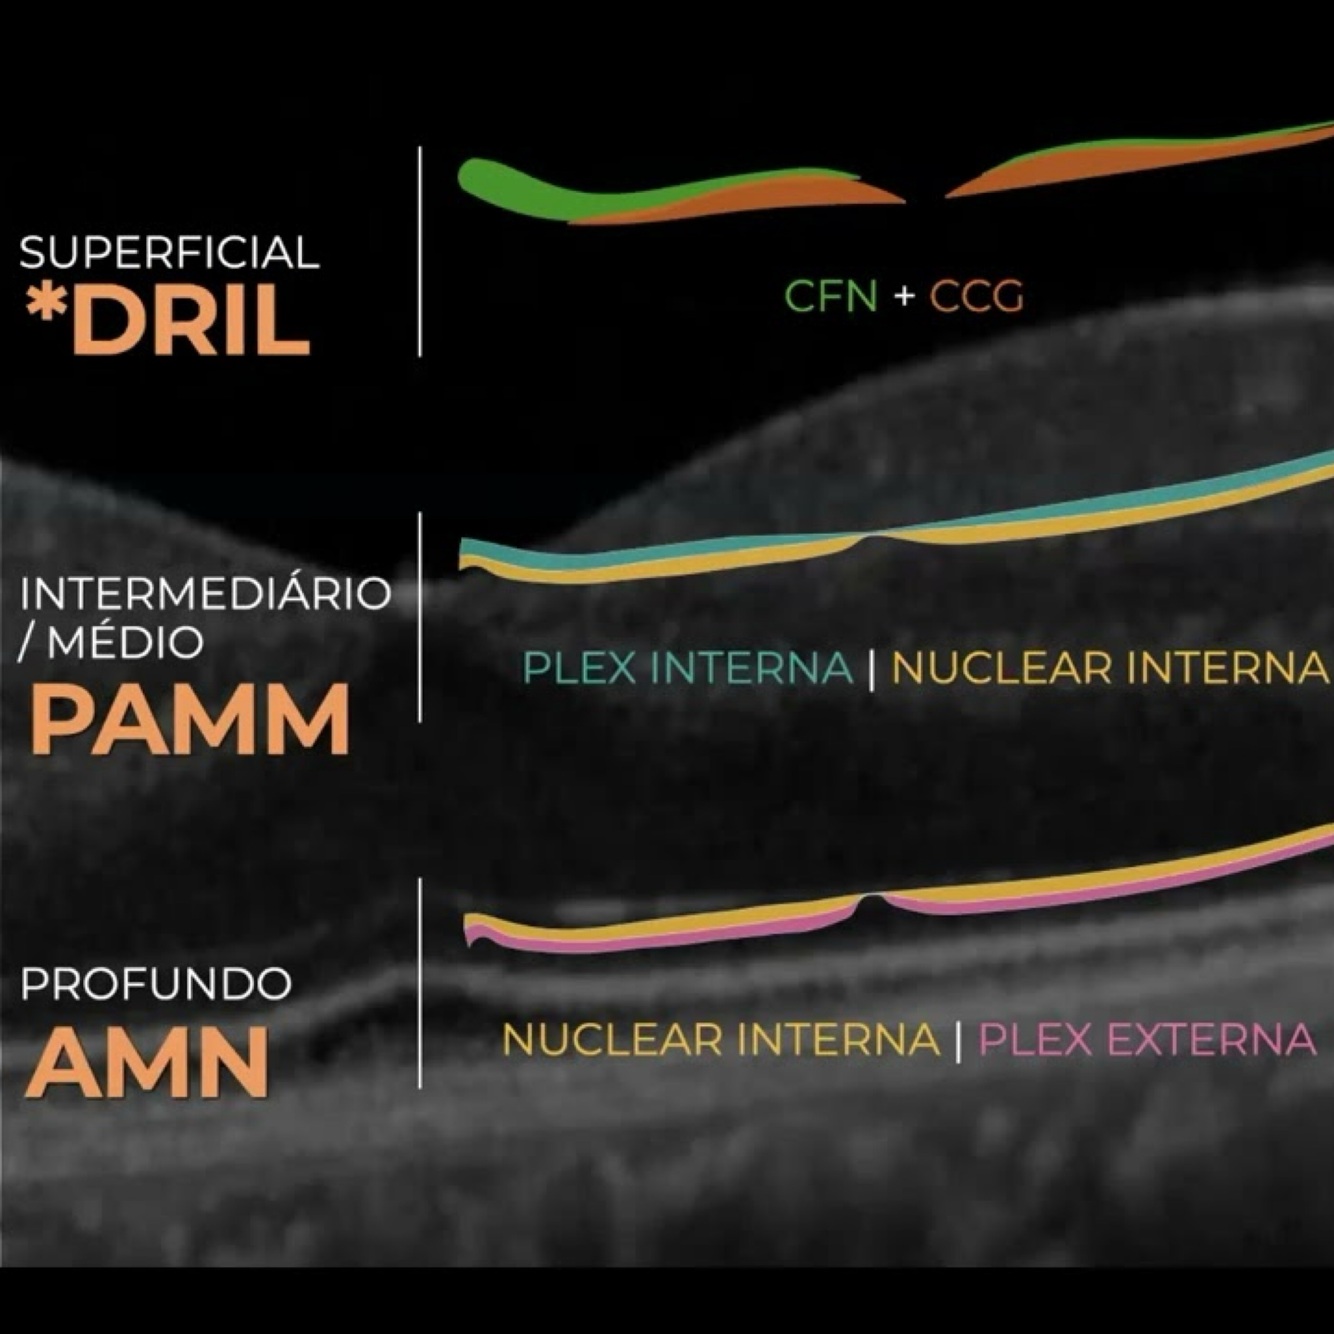
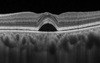

Autossomica dominante
Best - BEST 1
Viteliforme Foveomacular Adulto - PRPH2
Distrofia Areolar Central - PRPH2
Distrofia macular drusenoide - drusas familiares EFEMP1
Distrofia de Sorsby - TIMP3 / GUCY2D
Retinoblastoma - RB1 crom 13
VHL - gene VHL crom 3
Hemangioma cavernoso - SNC/pele
Esclerose Tuberosa/ Bourneville - TSC 1 e TSC2
Neurofibromatose NF1 e NF2
💙 Tritanopia
Stickler - colagenopatia 2 e 11
Sd Wagner- versican condroitina
Autossomica Recessiva
Retinose pigmentar : AR + comum
D. Cones: AR + comum
Stargardt: ABCA4
Amaurose congênita Leber: RPE65
Atrofia girata: OAT
D. Cristalina de bietti: Cyp4v2
🩶Acromatopsia tipica
Recessiva Ligada ao X
Coroideremia- CHM / proteina REP1
Retinosquise lig X - RS1
Cegueira noturna estacionaria
Albinismo ocular - ausencia enzima tirosina quinase (melanina)
💚Deuteranopia
❤️Protanopia
💙Acromatopsia atipica (monocromatismo azul)
DMRI gene
CFH principal
Regula via do complemento (C3), inflamação crônica
ApoE2: risco aumentado (metabolismo dos lipidios)
TIMP3 e ARMS2 - relação com DMRI neovascular
EFEMP1 - drusas dominantes (A.D)
C2 e CFB (Complement Factor B)
• Papel: moduladores da via do complemento clássico e alternativa.
• Algumas variantes conferem proteção contra DMRI.
ApoE4: fator protetor
Distrofia Mitocondrial - Kearns Sayre
Retinose pigmentar + OEP + bloqueio cardíaco (antes 20 anos)
Proteina no liquor e ataxia
Miopatia, surdez , alt endocrinas
Biopsia: ragged red fibers
Fo: sal e pimenta ou forma classica
PAMM - maculopatia
50-60 anos, histórico de vasculopatia previa (oclusões, vasoespasmos)
Escotoma paracentral subito
OCT: hiperrefletividade camada intermediaria- nuclear interna (em banda ou salteado* melhor progn)
OCT - a : padrão samambaia
AGF: geralmente normal
• OCT-A: redução do fluxo no plexo intermediário

AMN - neurorretinopatia

+ mulheres, 30 anos, prodromo viral
Uso de ACO, dengue, febre, COVID…
Escotoma paracentral agudo
Afeta mais a AV
OCT: hiperrefletivifade em banda na nuclear externa e zona elipsoide
Fo: aspecto em petala ou gota (near infrared)
• AGF : geralmente normal
• OCT-A: possível diminuição do fluxo no plexo capilar profundo
Ambas: watershad zone - evoluem para afilamento
O que é Camada de Henle
Esta dentro da camada nuclear externa, mas é composta pelos axônios dos cones que se dirigem obliquamente em direção à foveola.
• É mais proeminente na fóvea, onde os cones estão mais densos.
Contem processos axonais dos cones até as sinapses com os bipolares na camada plexiforme externa.
Dengue
TRIADE (HMG plaquetopenia)
1. Vasculite retiniana (sobretudo venosa)
2. Hemorragias retinianas
3. Edema macular

Mecanismo fisiopatológico
• Provavelmente imunomediado, não por invasão viral direta.
• Mais comum em fases tardias da infecção.
QC: Febre alta, mialgia, cefaleia retro orbitaria, plaquetopenia, NS1
Manchas “white spots” • Lesões hiper-reflexivas, semelhantes às síndromes de pontos brancos. Vasculite retiniana • Inflamação de arteríolas e vênulas → microinfartos.
Pode simular AMN **e PAMM
Neurite óptica (rara)

Zika virus

Pouca febre, exantema pruriginoso, mialgia leve, sorologia por PCR
Conjuntivite
Coloboma de macula se congenito (diagn. diferencial de TOXO)
Chikungunya
Artralgia e edema articular, febre alta
Uveite anterior
Mecanismo das arbovirores
• Replicação viral.
• Resposta inflamatória do hospedeiro (citocinas, interferons).
• Fenômeno de ADE (no caso da dengue) ou Potenciação Dependente de Anticorpos) é um mecanismo imunológico que pode piorar a infecção viral
Localização OCT das lesões do diabetes

Hemorragia em chama de vela: CFNR
Exsudato algodonoso: CFNR
microinfartos da retina → acúmulo de material axoplásmico
Exsudatos duros: lipoproteina na plexiforme externa
Ponto borrão: hemorragia na nuclear interna
IRMAs: shunts arteriola-venula na plexiforme e nuclear interna (não são neovasos)
EM diabético: retina interna
Mancha algodonosa: lesão superficial pequena e esbranquiçada, com hipo focal por isquemia na AGF - disrupção isquemica dos axonios
Classificação retinopatia diabetica
RDNP Leve:
• Apenas microaneurismas
(Se QUALQUER outra lesão, já não é leve)
RDNP Moderado
ETDRS - GRAVE 4:2:1
4 quadrantes de hemorragias intrarretinianas intensas
2 quadrantes de beading venoso (dilatação/tortuosidade)
1 quadrante de IRMA moderada/intensa
Maculopatia diabetica isquemica (não responde a VEGF)

Diabetes → lesão endotelial, perda pericitos → capilares maculares se fecham → áreas de não perfusão.
ZAF: > 400 micra
• Acuidade visual reduzida, mesmo sem edema aparente.
• Fundoscopia: áreas de palidez ou pequenos pontos algodonosos na mácula, microaneurismas podem estar presentes.
• Fluoresceinografia: mostra áreas de hipofluorescência correspondentes à não perfusão capilar foveal e parafoveal.
• OCT: espessamento pode estar ausente; às vezes há atrofia da retina interna, sem cistos típicos de edema.
Edema macular clinicamente significativo
- Edema que envolve ou ameaça envolver a mácula central (fovea).
- Exsudatos duros dentro de 500 μm da fovea.
- Espessamento retiniano dentro de 500 μm da fovea.
Obs.: 500 μm ≈ 1/3 do diâmetro do disco óptico.
O que é o DRCR .net
• É uma rede multicêntrica de investigação nos EUA, voltada para estudos em Retinopatia diabética (RD) e Edema macular diabético (EMD).
O que é o Protocol T
• Estudo randomizado que comparou três agentes anti‑VEGF Aflibercept, Ranibizumab e Bevacizumab.
• População: adultos com DM1 ou DM2, com EMD central que afeta a visão.
Todos os três medicamentos melhoraram visão em média.
• Importante: a diferença de eficácia entre os fármacos se relacionou ao nível de acuidade visual inicial.
• Em olhos com acuidade pré‑tratamento relativamente boa (por exemplo 20/32‑20/40), os resultados foram sem diferença clínica importante entre os três fármacos.
• Em olhos com acuidade pior (por exemplo ≤ 20/50), o aflibercept apresentou vantagem estatística e clínica sobre bevacizumabe, e também sobre ranibizumabe em determinado cenário.
• Em termos anatômicos (espessura da mácula no OCT): aflibercept reduziu mais a espessura central em alguns casos.
• Segurança: não houve diferença relevante em eventos adversos graves entre os grupos naquele estudo.
Resumo:
Eylea foi superior se AV inicial menor 20/50 e teve mais ganhos de letras (~13), tem vantagem no primeiro ano de tratamento (no 2 ano, essas diferenças reduzem)
Os estudos RISE e RIDE (fase III) Edema Macular Diabético (EMD) com envolvimento da mácula central
Ranibizumabe (0,3 mg ou 0,5 mg) a cada 4 semanas. X SHAM (placebo)
• Critérios de inclusão principais: pacientes adultos com diabetes tipo 1 ou tipo 2, com EMD que afetava visual (acuidade 20/40 a 20/320) e espessamento central da mácula (CST ≥ 275 µm) no OCT.
No 24º mês:
• Em RISE: taxa de ganho ≥15 letras foi 44,8% (0,3 mg) e 39,2% (0,5 mg) vs 18,1% no grupo sham.
• Em RIDE: taxa de ganho ≥15 letras foi 33,6% (0,3 mg) e 45,7% (0,5 mg) vs 12,3% no sham.
• Redução significativa da espessura foveal central (CST) no grupo ranibizumabe vs sham.
• Resultados de 36 meses: ganhos de visão e anatomia foram mantidos nos grupos tratados originalmente com ranibizumabe; o braço sham que posteriormente cruzou teve ganhos menores.
Resumo: primeiro grande estudo que aprovou o Lucentis. Indicado tratamento precoce para melhores resultados. Efeito mantido com o tto continuo.
VIVID‑DME e VISTA‑DME (frequentemente abreviados para VIVID e VISTA) de 2014‑2015 são ensaios de fase III importantes para o tto EMD
1. Aflibercept 2 mg a cada 4 semanas (2q4) 2. Aflibercept 2 mg a cada 8 semanas após 5 doses mensais (2q8) 3. Fotocoagulação a laser macular (controle)

O estudo demonstra que aflibercept é superior à fotocoagulação laser para CI‑DME em termos de visão e anatomia.
• A dosagem a cada 8 semanas após indução (2q8) apresentou eficácia comparável à dosagem mensal (2q4) em muitos parâmetros, o que pode ter implicações para carga de tratamento.
• Importante: os resultados foram mantidos a médio‑longo prazo (100 semanas e depois até 148 semanas em análises adicionais).
• Em pacientes com CI‑DME, considerar tratamento com anti‑VEGF (como aflibercept) em vez de laser como primeira linha, especialmente se houver redução visual ou espessamento central significativo.
Resumo: a dose bimensal mostrou eficacia ~ a mensal, com menos IVTs

Yosemite e Rhine - EMD
- Faricimab (Vabysmo) 6,0 mg a cada 8 semanas (Q8W) após carga inicial.
- Faricimab 6,0 mg com regimen personalizado (PTI = personalized treatment interval ou “treat-and-extend”), possível até Q16W (todas as 16 semanas) conforme critérios de controle.
- Aflibercept 2,0 mg Q8W (com carga inicial) como comparador-ativo.
Em termos anatômicos: em análise post hoc, ambos os braços de faricimab mostraram reduções maiores da espessura (CST) e maior % de olhos com ausência de fluido intrarretiniano ou sub-retiniano, comparados ao aflibercept. 
• Durabilidade: Com faricimab no regime PTI, muitos olhos conseguiram estender intervalo até 12-16 semanas sem perda de eficácia.
• Em visão: O efeito visual foi comparável ou melhor em alguns subgrupos com faricimab versus aflibercept, inclusive em pacientes com BCVA inicial pior (20/50 ou pior).
Faricimab oferece uma opção com potencial de menor fardo de injeções (intervalos maiores) mantendo eficácia.
• Para pacientes com visão já muito comprometida ou que têm dificuldade em comparecer com frequência, o regime “estendido” pode ser uma vantagem.
Consegue estender ate 16 semanas!
DRCR.net PROTOCOLO I
- Ranibizumabe + laser imediato
- Ranibizumabe + laser adiado (≥24 semanas)
- Triancinolona + laser
- Laser isolado (grupo controle)
Todos receberam o laser focal/grid conforme diretrizes do ETDRS.
Injeções de ranibizumabe (0,5 mg) mensais inicialmente, depois conforme necessidade (pro re nata).
🔹 Melhor resultado visual: Ranibizumabe + laser adiado
🔹 Efeito colateral: Triancinolona → catarata e aumento de PIO.
🔹 Nos pseudofácicos, o grupo da triancinolona teve eficácia semelhante ao ranibizumabe
🧩 Conclusões
• Ranibizumabe + laser adiado = melhor ganho visual sustentado.
• Laser isolado deixa de ser o tratamento padrão — anti-VEGF passa a ser primeira linha para EMD
• O laser ainda pode ser usado como complemento, especialmente quando o edema é focal e residual.
• Triancinolona pode ser opção em pseudofácicos ou em quem não pode usar anti-VEGF
🩺 Seguimento longo (5 anos)
• Ganhos visuais mantidos nos grupos ranibizumabe.
• Redução na necessidade de injeções após o segundo ano.
• A proporção de olhos livres de edema aumentou ao longo do tempo.
Bevacizumab (Avastin)
• Anticorpo monoclonal humanizado IgG1
• Anti-VEGF-A (Fator de Crescimento Endotelial Vascular A)
• Originalmente desenvolvido para uso oncológico sistêmico (carcinoma colorretal metastático), mas usado off-label na oftalmo
O bevacizumabe se liga com alta afinidade ao VEGF-A (todas as suas isoformas), impedindo que ele ative seus receptores (VEGFR-1 e VEGFR-2) na superfície das células endoteliais.
1,25 mg/0,05 mL usual:
• Meia-vida: ~7–10 dias.
• Efeito terapêutico: 4–6 sem.
• Pequena absorção sistêmica (raros)
- Hipertensão arterial.
• Eventos tromboembólicos (AVC, IAM — pacientes de alto risco).
• Proteinúria, microangiopatia (em uso sistêmico).
Aflibercept (Eylea)
• Proteína de fusão recombinante (não é anticorpo).
• Também chamada de VEGF-Trap (“armadilha para VEGF”).
• É formado pela fusão das porções extracelulares dos receptores VEGFR-1 e VEGFR-2 com a fração Fc da IgG1 humana.
• Liga-se com altíssima afinidade ao VEGF-A, VEGF-B e PlGF (placental growth factor).
• Ao se ligar a esses fatores, impede que eles ativem os receptores endoteliais, bloqueando:
1. Angiogênese patológica.
2. Aumento permeabilidade vascular (edema).
2 mg/0,05 mL.
• Meia-vida vítrea: cerca de 7 dias, mas com atividade biológica mais longa → permite aplicações mais espaçadas (até a cada 8–16 semanas).
• Ligação muito estável ao VEGF → maior duração clínica comparado a ranibizumabe e bevacizumabe.

Ranibizumab (Lucentis)
Fragmento Fab humanizado de um anticorpo monoclonal anti-VEGF-A.
• Desenvolvido a partir do bevacizumabe, mas com menor peso molecular → melhor penetração nas camadas da retina.
Liga-se especificamente ao VEGF-A (todas as isoformas).
• Impede que o VEGF se ligue aos seus receptores endoteliais (VEGFR-1 e VEGFR-2).
0,5 mg/0,05 mL intravítreo.
• Meia-vida vítrea: ~9 dias.
• Desvantagem de varias Injeções mensais no inicio, mas regimes treat & extend ou PRN podem ser usados.
• Baixa absorção sistêmica → menor risco de eventos tromboembólicos que bevacizumabe.